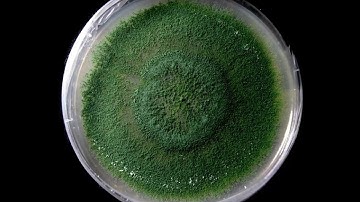
Trichoderma Viride Timelapse

⬇ DOWNLOAD NOW
Kalau muncul iklan pop-up, tutup lalu klik tombol kembali
Download lagu Research Methods: Trichoderma viride v. Neolentinus lepideus secara gratis hanya untuk keperluan promosi. Dukung artis favorit kamu dengan membeli musik original di iTunes atau platform resmi lainnya.
 Hernandez: Research Methods Video Presentation 12.10.17
Hernandez: Research Methods Video Presentation 12.10.17
 How do Trichoderma work? Atens explain it to you
How do Trichoderma work? Atens explain it to you
 How Nematodes Damage Plants
How Nematodes Damage Plants
 Trichoderma culture and Microscopic observation
Trichoderma culture and Microscopic observation
 Nematodes and Crop Protection I 360° Video
Nematodes and Crop Protection I 360° Video
 Trianum (Trichoderma harzianum) - How does it work?
Trianum (Trichoderma harzianum) - How does it work?
Trichoderma Viride Timelapse
Trichoderma Viride Timelapse
 Mycorrhizal Fungi Animation
Mycorrhizal Fungi Animation